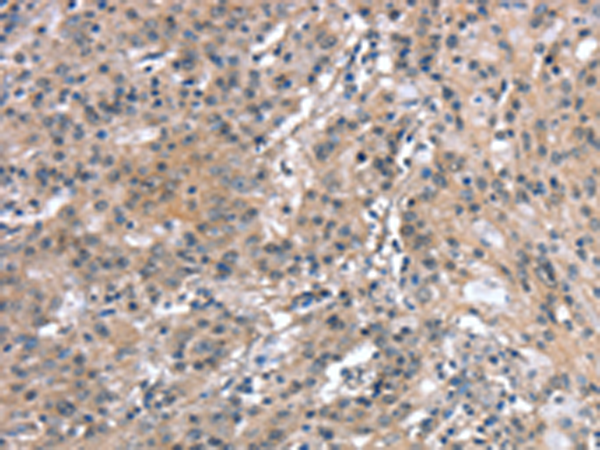
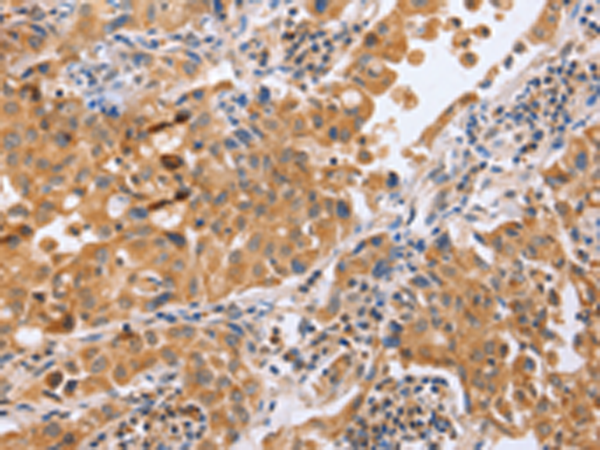

-
分类: 科研抗体货号: P11603别名: VHO; BMP11; BMP-11应用: WB反应种属: Human, Mouse, Rat
-
分类: 科研抗体货号: P11586别名: ELG1; FRAG1; C17orf41应用: WB反应种属: Human
-
分类: 科研抗体货号: P11621别名: CAPZ; CAZ1; CAPPA1应用: IHC反应种属: Human, Mouse, Rat
-
分类: 科研抗体货号: P11602别名: VGR; VGR1应用: IHC反应种属: Human, Rat
-
分类: 科研抗体货号: P11585别名: ASIC; ACCN2; BNaC2应用: IHC反应种属: Human, Mouse, Rat
-
分类: 科研抗体货号: P11620别名: MTB; CAPG2; LUZP5; CAP-G2; hCAP-G2应用: IHC反应种属: Human
-
分类: 科研抗体货号: P11601别名: GTB; NAGAT; A3GALNT; A3GALT1应用: IHC反应种属: Human
-
分类: 科研抗体货号: P11584别名: ALAP; A-LAP; ARTS1; ERAAP; APPILS; ARTS-1; ERAAP1; PILSAP; PILS-AP应用: WB反应种属: Human
-
分类: 科研抗体货号: P11600别名: bca; AGM4; BASH; LY57; SLP65; BLNK-S; SLP-65应用: WB,IHC反应种属: Human, Mouse, Rat
-
分类: 科研抗体货号: P11619别名: CANPMR应用: WB反应种属: Human, Mouse

鄂公网安备42018502007531号
鄂公网安备42018502007531号

